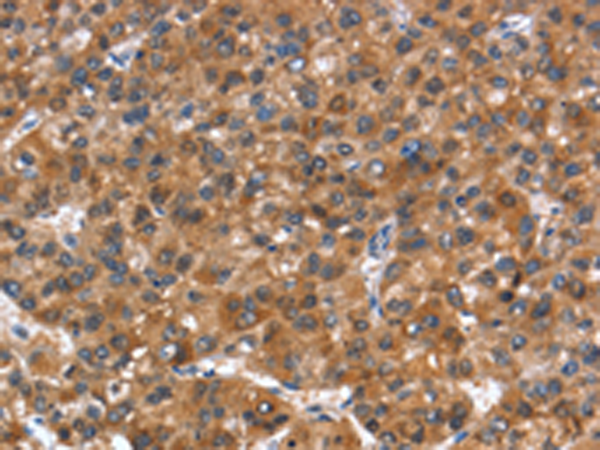

中文名稱: 兔抗NOD2多克隆抗體
英文名稱: Anti-NOD2 rabbit polyclonal antibody
別 名: CD; ACUG; BLAU; IBD1; NLRC2; NOD2B; CARD15; CLR16.3; PSORAS1
相關(guān)類別: 一抗
儲 存: 冷凍(-20℃)
宿 主: Rabbit
抗 原: NOD2
反應(yīng)種屬: Human
標(biāo) 記 物: Unconjugate
克隆類型: rabbit polyclonal
技術(shù)規(guī)格
|
Background: |
This gene is a member of the Nod1/Apaf-1 family and encodes a protein with two caspase recruitment (CARD) domains and six leucine-rich repeats (LRRs). The protein is primarily expressed in the peripheral blood leukocytes. It plays a role in the immune response to intracellular bacterial lipopolysaccharides (LPS) by recognizing the muramyl dipeptide (MDP) derived from them and activating the NFKB protein. Mutations in this gene have been associated with Crohn disease and Blau syndrome. |
|
Applications: |
ELISA, IHC |
|
Name of antibody: |
NOD2 |
|
Immunogen: |
Synthetic peptide of human NOD2 |
|
Full name: |
nucleotide-binding oligomerization domain containing 2 |
|
Synonyms: |
CD; ACUG; BLAU; IBD1; NLRC2; NOD2B; CARD15; CLR16.3; PSORAS1 |
|
SwissProt: |
Q9HC29 |
|
ELISA Recommended dilution: |
1000-2000 |
|
IHC positive control: |
Human liver cancer and Human thyroid cancer |
|
IHC Recommend dilution: |
25-100 |
購物車
幫助
021-54845833/15800441009
